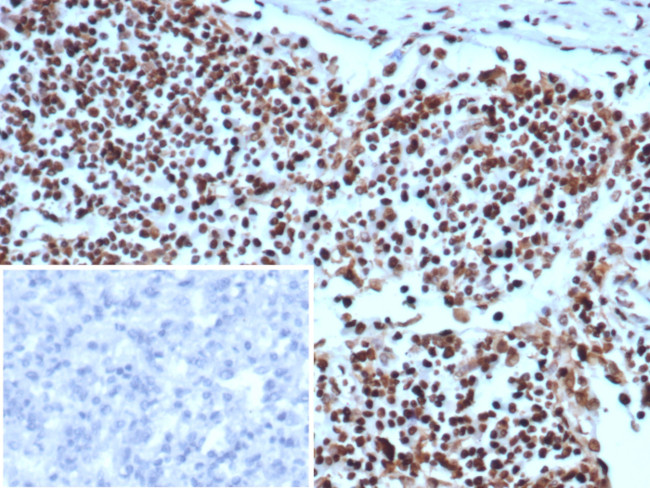
XRCC5 (Ku86/Ku80) (Thyroid-Lupus Autoantigen) Antibody in Immunohistochemistry (Paraffin) (IHC (P))

Search
NeoBiotechnologies
XRCC5 (Ku86/Ku80) (Thyroid-Lupus Autoantigen) Monoclonal Antibody (XRCC5/7314)
{{$productOrderCtrl.translations['antibody.pdp.commerceCard.promotion.promotions']}}
{{$productOrderCtrl.translations['antibody.pdp.commerceCard.promotion.viewpromo']}}
{{$productOrderCtrl.translations['antibody.pdp.commerceCard.promotion.promocode']}}: {{promo.promoCode}} {{promo.promoTitle}} {{promo.promoDescription}}. {{$productOrderCtrl.translations['antibody.pdp.commerceCard.promotion.learnmore']}}
产品信息
7520-MSM4-P0
种属反应
宿主/亚型
分类
类型
克隆号
抗原
偶联物
形式
浓度
纯化类型
保存液
内含物
保存条件
运输条件
靶标信息
The protein encoded by this gene is the 80-kilodalton subunit of the Ku heterodimer protein which is also known as ATP-dependant DNA helicase II or DNA repair protein XRCC5. Ku is the DNA-binding component of the DNA-dependent protein kinase, and it functions together with the DNA ligase IV-XRCC4 complex in the repair of DNA double-strand break by non-homologous end joining and the completion of V(D)J recombination events. This gene functionally complements Chinese hamster xrs-6, a mutant defective in DNA double-strand break repair and in ability to undergo V(D)J recombination. A rare microsatellite polymorphism in this gene is associated with cancer in patients of varying radiosensitivity.
仅用于科研。不用于诊断过程。未经明确授权不得转售。
篇参考文献 (0)
生物信息学
蛋白别名: 86 kDa subunit of Ku antigen; ATP-dependent DNA helicase 2 subunit 2; ATP-dependent DNA helicase II 80 kDa subunit; CTC box-binding factor 85 kDa subunit; CTC85; CTCBF; DNA repair protein XRCC5; FLJ39089; HGNC:12833; Ku autoantigen, 80kDa; Ku-80; Ku-86; Ku80; Ku86; Ku86 autoantigen related protein 1; Lupu; lupus; Lupus Ku autoantigen protein p86; Nuclear factor IV; OTTHUMP00000164061; OTTHUMP00000206791; Thyroid-lupus autoantigen; TLAA; X-ray repair complementing defective repair in Chinese hamster cells 5 (double-strand-break rejoining); X-ray repair cross-complementing protein 5
基因别名: G22P2; KARP-1; KARP1; KU80; Ku86; KUB2; NFIV; XRCC5
UniProt ID: (Human) Q53HH7
Entrez Gene ID: (Human) 7520